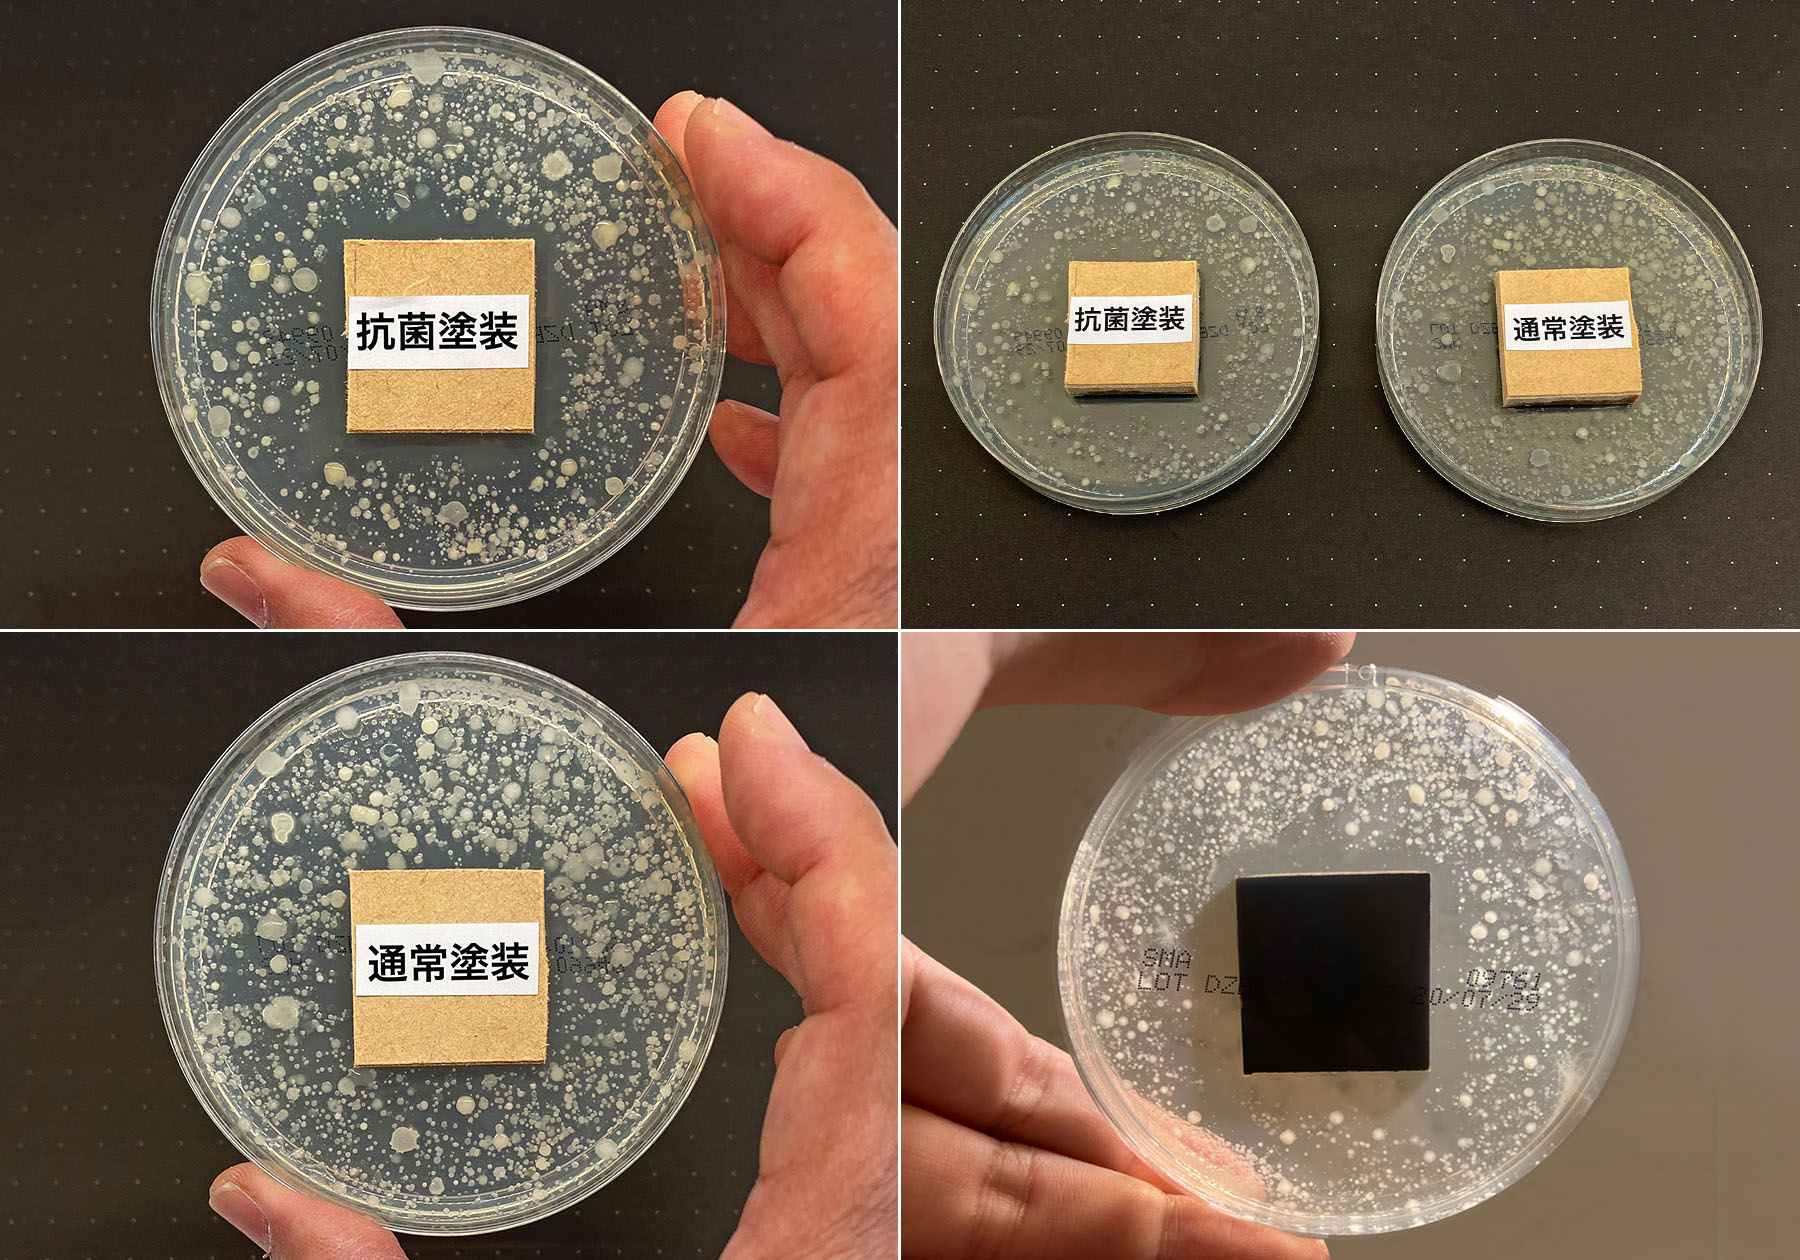

AD CORE DEVISE PRODUCT BLOG vol.85
エーディコア・ディバイズでは新型コロナウイルスの感染拡大をうけ、より製品を安心してお使いいただけるようオプションとして抗菌塗装をご用意しております。抗菌塗料の持つ抗菌性能についての公的な試験結果は確認していますが、目に見える効果があればよりお客様にご納得いただけ、当社としても自信を持ってお勧めできると考え社内で実験を行いました。
実験はJIS L1902:ハロー法の試験に基づいて行いました。
ハロー法の試験方法とは円形、または正方形にカットした抗菌加工繊維製品を試験菌を含む寒天平板培地の中央部に置き、37℃で24〜48時間培養します。培養後、試験片の周囲にできたハロー(発育阻止帯:細菌の発育がない透明な部分)の長さを測定します。培養後の試料の周囲にハローがあれば「抗菌性あり」と判定します。今回当社の実験では培養寒天は試験用の標準寒天を使用。試験用の細菌は黄色ブドウ球菌や大腸菌などが専門機関でなければ手に入らないため、腐葉土10gに精製水50mlを加え攪拌後沈殿させた上澄みの水を培養寒天に塗布しました。その中央部に通常の塗装と抗菌塗装の2種類を30mm角にカットし、それぞれ塗装面を培養寒天に触れるように置いて、培養器を使用し温度36度を24時間キープし細菌の増殖、ハローを確認しました。
結果は下の写真も併せてご覧ください。
通常塗装:全体に細菌のコロニーが見えて、塗装板に密着。
抗菌塗装:塗装板の周りにハロー現象が見られ、塗装板に細菌のコロニーが接近できず。
抗菌塗装は通常の塗装と同じ仕上がりで見分けはつきませんが、今回の実験を通し目に見える形で抗菌効果を確認することができました。通常の抗菌試験では電子顕微鏡を用いた結果を数字として専門機関からいただく形ですので、目視できる効果を確認いただき、当社の家具をより安心してお使いいただけたらと思います。まだまだ先行きが見えない中ではありますが、エーディコア・ディバイズではより安心で安全な製品づくりに努めてまいります。抗菌塗装だけではなく、抗菌対応ファブリックもご用意しておりますので是非ご検討ください。
(エーディコア・ディバイズ 開発部/富所 駿)
■ [AD+AC] 抗菌対応のマテリアルをご用意しました ■
■ 抗菌塗装無料キャンペーン中 ■